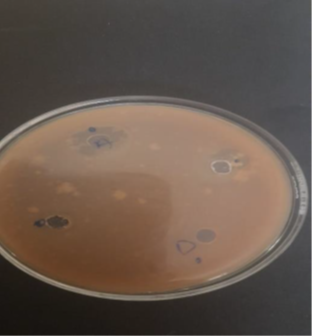

We use cookies to ensure our website works properly and to personalise your experience. Cookies policy

We use cookies to ensure our website works properly and to personalise your experience. Cookies policy
1,3,4,6 Vishnu Institute of Pharmaceutical Education and Research, Narsapur, Medak, Telangana - 502313, India.
2 G. Pulla reddy college of pharmacy, Mehdipatnam, Hyderabad-500028
5 Department of Chemistry, School of Science, GITAM University, Hyderabad, 502102, India
These days, herbal lipsticks are getting more and more popular because natural cosmetics are easy for women to apply and safe. Artificial coloring compounds have been shown to be carcinogenic and to trigger allergic reactions. Our research aims to create and assess herbal lipstick by employing edible, natural coloring agents like beetroot and watermelon. Using a variety of organic substances, including wax, butter, coconut oil, olive oil, castor oil, vanilla, rose essence, and lemon juice, bees were employed to produce herbal lipsticks. Herbal lipsticks were assessed and contrasted with the industry standard formulation in various tests, including surface irregularities, aging, pH, colour, texture, Perfume, liquid point, softening point, and breaking point durability.
Herbal lipsticks, also known as vegan lipsticks, are cosmetics made from natural and plant-based ingredients. These lipsticks are free from synthetic dyes, fragrances, and other harmful chemicals, making them a popular choice for individuals looking for natural and organic beauty products, potentially causing irritation or allergic reactions1. In addition to providing stunning shades and long-lasting wear, herbal lipsticks often contain nourishing ingredients such as coconut oil, shea butter, and botanical extracts, offering moisturizing benefits for the lips. This combination of vibrant color and skin-loving properties has contributed to the growing popularity of herbal lipsticks in the beauty industry2. Herbal lipsticks have gained traction not only for their cosmetic benefits but also for their potential health benefits.
1.1 PLANT PROFILE:


Fig: 1 Mirabilis Jalapa Linn (C27H30O16)
Scientific Name: Mirabilis Jalapa Linn
Common Names: Four O' Clock flower, Marvel of Peru, Beauty of the Night
Family: Nyctaginaceae
Origin: Native to tropical regions of South America, particularly Peru and Mexico.
Habit: Mirabilis Jalapa is a perennial herbaceous plant that can grow up to 1-4 feet (30-120 cm) tall.
Leaves: The leaves are ovate to lanceolate, green, and arranged alternately along the stem.
Flowers: The flowers are the most distinctive feature of Mirabilis Jalapa. They are trumpet shaped, fragrant, and come in a variety of hues, such as pink, red, yellow, white, and bi-colors. The flowers typically open in the late afternoon, which leads to the common name "Four O 'Clock flower," and remain open until the following morning3.
Fruit: After flowering, Mirabilis Jalapa produces small, round, fleshy fruits that contain seeds.
Growth Habit: It has a bushy growth habit and can spread easily, making it suitable for use as a bedding plant or in mixed borders.
2. MATERIALS AND METHODS:
Table: 1 List of the Material used:
|
Sr. No |
Materials |
Category |
|
1 |
Extract of flowers of Mirabalis Jalapa Linn |
Herbal extract / Natural plant extract |
|
2 |
Carnauba wax |
Wax / Emollient / Thickening agent |
|
3 |
Ozokerite wax |
Mineral wax / Thickening agent |
|
4 |
White soft paraffin |
Base / Emollient / Ointment base |
|
5 |
Lemon juice |
Natural acidic agent / Antioxidant / Flavoring |
|
6 |
Vitamin E |
Antioxidant / Skin conditioning agent |
|
7 |
Moringa oil |
Fixed oil / Emollient / Nutrient oil |
|
8 |
Castor oil |
Fixed oil / Emollient / Humectant |
|
9 |
Bees wax |
Natural wax / Thickening agent / Film-forming agent |
2.2 Method:
2.2.1 Extraction of Colour from Mirabalis Jalapa Linn Flowers:
The flowers Mirabilis Jalapa Linn (also named as four o'clock flower) were collected from the forest area of Narsapur. Coarse powder is prepared by shade drying the flowers and mechanical agitation. Herbal fractionation was achieved by method of maceration was adapted to fractionate the various bioactive components from the flowers Mirabilis Jalapa Linn4. Filter, concentrate the extract and store in desiccator and utilized for formulation.
Table: 2 Formulation table:
|
Sr.No |
Ingredients |
F1 |
F2 |
F3 |
|
1 |
Extract |
5 gm |
10 ml |
15 ml |
|
2 |
Bees wax |
2 gm |
2 gm |
2 gm |
|
3 |
Carnauba wax |
0.5gm |
0.5gm |
0.5gm |
|
4 |
Ozokerite wax |
2 gm |
2 gm |
2 gm |
|
5 |
Castor oil |
1 ml |
1 ml |
1 ml |
|
6 |
Lemon juice |
0.1ml |
0.1ml |
0.1ml |
|
7 |
Vitamin E |
0.1ml |
0.1ml |
0.1ml |
|
8 |
Moringa oil |
1ml |
1 ml |
1 ml |
|
9 |
White soft paraffin |
1gm |
1gm |
1gm |
|
10 |
Vanilla essence |
0.1ml |
0.1ml |
0.1ml |
3. PROCEDURE:
Equal quantities of all ingredients except wax were transferred into three individual beakers. Add 5 milliliters of colored pigment to them the melted wax were added in the manner of bees wax, carnauba wax respectively. Allow to cool the mixture to 40°C, add vanilla essence5. Formulations (F1, F2 and F3) were prepared and molded using a Silica mold. After solidified, they were removed from the molds and put inside the lipstick casing.



Fig no.6: Formulation of Lipstick (F1, F2, F3)
4. EVALUATION TESTS:
The evaluation studies are essential for determining the efficiency, stability, and homogeneity of the finished product. The tests performed to assess the lipsticks are as follows:
4.1 Melting point:
Finding the melting point is crucial since it shows the upper bound for safe storage. Melt the materials and then transfer them into a 50 mg glass capillary tube that has been opened on both ends. Cool the mixture with ice for two hours and then use a thermometer to determine the melting point. Utilize a thermometer submerged in water in a beaker set above a heated plate stirrer. Slowly heating and stirring were started at a set pace6. As the lipstick sample traveled along the capillary tube, the melting point was measured. The melting point was measured using a digital melting point device.
4.2 Test for Application Force:
In this test, the amount of pressure to be provided is measured in relation to its actual application. On a sheet of fine brown paper lying on a shadow graph balance, a square inch was entirely covered with lipstick applied at an angle of 45°. The pressure readout indicates the force applied. Applying lipstick to a sheet of paper at a 45-degree angle allowed researchers to measure the firmness of the product; the pressure employed during application determined the application force7.
4.3 Solubility:
The setup for the solubility test, Solvents was used to melt a range of herbal lipsticks. Different solvents were used to disseminate the herbal lipstick composition.To describe the solvent selectivity of lipstick, a solubility test can reveal the polarity of the chemical. A few drops of the lipstick sample should be added to various solvents, including petroleum ether, methanol, ethanol, and chloroform8. It was found that the lipstick was soluble in ethanol and methanol. Castor oil-containing lipstick has a limited solubility in petroleum solvents but is soluble in alcohol.
4.4 pH Test:
The permitted bounds of the products to be applied on the lips safely are defined by the pH stability profile and the safe pH range for lipsticks. A product's microbiological and physical stability may change depending on the pH levels. The skin barrier may be harmed by an extreme pH. Healthy lips have an average pH of 4.7. The pH of lipstick formulas was measured using a potentiometric technique with a pH meter device. Nonetheless, lipstick that was suitable to use on the lips had to have a pH of between 4 and 79.
4.5 Tests for Rancidity:
Oxidation of oils, like castor oil, and many other substances can lead to a sticky product, as well as an unpleasant taste and odor. Hydrogen peroxide can be used to test for rancidity, and its peroxide number can be found.

Fig. no: 7 Rancidity Test
4.6 Spreadability Test:
After applying the lipstick sample between the two glass slides 50 grams of weight was placed there for two minutes to compress it to a uniform thickness.


Fig. no: 8 Spreadability Test
4.7 Skin Irritation:
In several researches, human models were used to evaluate lipsticks for skin irritation. The skin (lip) was covered with the prepared lipstick. Any signs, including itchiness. Over the course of ten minutes, redness and irritation were seen. It was also proposed that the lipsticks' skin irritation test be conducted using a rabbit model. Three rabbits were chosen, divided into two groups, and put through a series of tests10. One rabbit was given commercial lipstick for the test group, and another rabbit received a lipstick sample. The rabbit test group was compared to the control group for any skin irritation on the treated area. It is important to note that cosmetic testing on animals is prohibited in several countries and is not advised13.

Fig. no: 9 Skin Irritations
4.8 Microbial Quality Control Test for Lipstick:
Lipstick manufacturers conduct microbial quality control tests to ensure their products are safe for consumers. These tests identify the presence of bacteria, fungi, and other microorganisms that could cause contamination11. Here are some common methods used for microbial quality control testing of lipsticks: Total aerobic plate count: This test measures the total number of viable aerobic bacteria and fungi present in a sample. Mold and yeast testing: This test specifically identifies the presence of mould and yeast in a sample. Pathogen testing: This test looks for specific harmful bacteria such as E. coli, Salmonella, and Staphylococcus aureus. Lipstick manufacturers typically set acceptable limits for microbial counts. Products that exceed these limits are rejected to ensure consumer safety12.

Fig. no: 9 Microbial Tests
4.9 Stability Study:
5. RESULTS AND DISCUSSION:
The current study's objective was to make a lipstick with herbal components to lessen the harmful effects of synthetic ones that are currently on the market.In current formulation of lipstick we formulated 3 formulations. In the formula 1 we used 3 waxes and 3 oils, lemon juice, white soft paraffin, 5ml of extract. In this process we didn't get the color for lipstick.
In the formula 2 we used 3waxes and 3oils, lemon juice, white soft paraffin, 10 ml of extract in this process we got light pink shade for lipstick. In the formula 3 we used 3waxes and 3oils, lemon juice, white soft paraffin, 15 ml of extract in this process we got dark pink shade for lipstick. From the above 3 formulations the formula 3 is best one.
Table: 3 Evaluation parameters and results:
|
Sr. No. |
Parameters |
F1 |
F2 |
F3 |
|
1 |
color |
Light pinkish |
pinkish |
Dark pinkish |
|
1 |
Melting point (OC) |
50-55 |
55-60 |
60 – 70 |
|
2 |
Breaking point |
5-6 |
6-8 |
6-10 |
|
3 |
Force of application |
Satisfactory |
Satisfactory |
Good |
|
4 |
pH parameters |
6.8+0.1 |
6.5+0.3 |
6.5+0.2 |
|
5 |
Aging stability |
Smooth |
Smooth |
Smooth |
|
6 |
Perfume stability |
Good |
Good |
Good |
|
7 |
Spreadability |
Good |
Good |
Good |
|
8 |
Color and texture |
Good |
Good |
Good |
|
9 |
Skin irritation |
No irritation |
No irritation |
No irritation |
|
10 |
Microbial activity |
Not observed |
Not observed |
Not observed |
|
11 |
Rancidity |
Not found |
Not found |
Not found |
|
12 |
Surface anomalies |
No defect |
No defect |
No defect |
CONCLUSION:
In addition to being able to shield the skin from UV radiation, natural cosmetics are said to be safer than cosmetics made of chemicals. Nowadays, lip color in the form of crayons, or lipstick, is one of the most popular cosmetics. It can be used as a natural or chemical makeup. The development of natural cosmetic components must go hand in hand with improving the quality of the raw materials used in the extracts. Because there are many variables that influence the amount and composition of active chemicals in a plant, it is not assured that raw materials will contain homogenous active ingredients both qualitatively and quantitatively.
As a result, industry researchers must standardize raw material extracts from natural sources. Therefore, the goal of this study was to develop and evaluate herbal lipsticks using castor oil as a foundation and standardized Mirabilis jalapa. In order to create a lipstick with fewer negative effects than synthetic ones, the current study's creation and evaluation of lipsticks using herbal elements was undertaken. The conclusions reached for the completed work are as follows: Three distinct formulas (F1–F3) were used to successfully create a lipstick with herbal components. The F3 formulations performed well out of the six formulations. It was discovered that the F3 formulation lipstick with herbal elements passed every evaluation test.
REFERENCES






G. Shravani, Ayesha Praveen, G. Latha, Hafsa, P. Hema Sree, V. Venkatesh, Preparation and Evaluation of Herbal Lipsticks of Mirabalis jalapa Linn, Int. J. of Pharm. Sci., 2026, Vol 4, Issue 1, 1337-1343. https://doi.org/10.5281/zenodo.18244953
 10.5281/zenodo.18244953
10.5281/zenodo.18244953